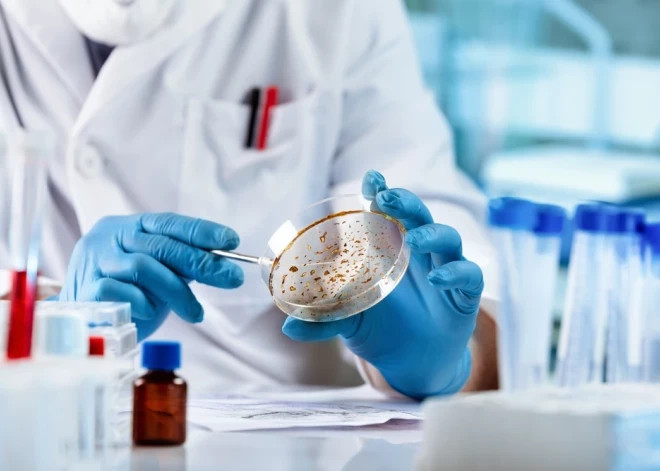
Врачи предупредили, что десятки тысяч людей в Латвии находятся в большой опасности

Врачи предупредили, что десятки тысяч людей в Латвии находятся в большой опасности

Повышенный уровень липопротеина, или Lp(a), может быть примерно у 20% жителей Латвии, то есть почти у 400 000 человек. С таким заявлением выступило общество ParSirdi.lv.
В обществе поясняют, что Lp(a) является генетически обусловленным фактором риска, который может быть повышен уже с рождения и остается неизменным на протяжении всей жизни. Согласно мировым исследованиям, в Латвии повышенный уровень липопротеина может быть примерно у 375 000 человек, а очень высокий и опасный — у 4%–5% населения, то есть примерно у 90 000 человек. В то же время менее 1% жителей когда-либо проверяли этот показатель, подчеркивают в обществе.
У большинства людей с повышенным уровнем липопротеина нет заметных симптомов, поэтому единственный способ его определить — анализ крови. Повышенный уровень липопротеина существенно увеличивает риск сердечно-сосудистых заболеваний, включая инфаркт, инсульт и сужение аортального клапана.
По данным общества, на каждые 10 000 обследованных можно предотвратить примерно 60 инфарктов, 13 инсультов и 26 случаев преждевременной смерти.
Хотя в настоящее время еще нет медикаментов, направленных непосредственно на лечение Lp(a), своевременное определение этого показателя позволяет врачам более эффективно контролировать другие факторы риска сердечно-сосудистых заболеваний и тем самым снижать вероятность осложнений.
Данный анализ достаточно выполнить один раз в жизни, однако в настоящее время в Латвии он не компенсируется государством.
Повышенным считается уровень липопротеина, превышающий 50 миллиграммов на децилитр, или 105 наномолей на литр. Если же уровень Lp(a) значительно повышен — выше 150 миллиграммов на децилитр, или выше 315 наномолей на литр, — общество призывает связаться с Латвийским регистром семейной гиперхолестеринемии.
Ранее Otkrito.lv сообщал о том, что после выхода на пенсию у жителей Латвии здоровья почти не остается.



